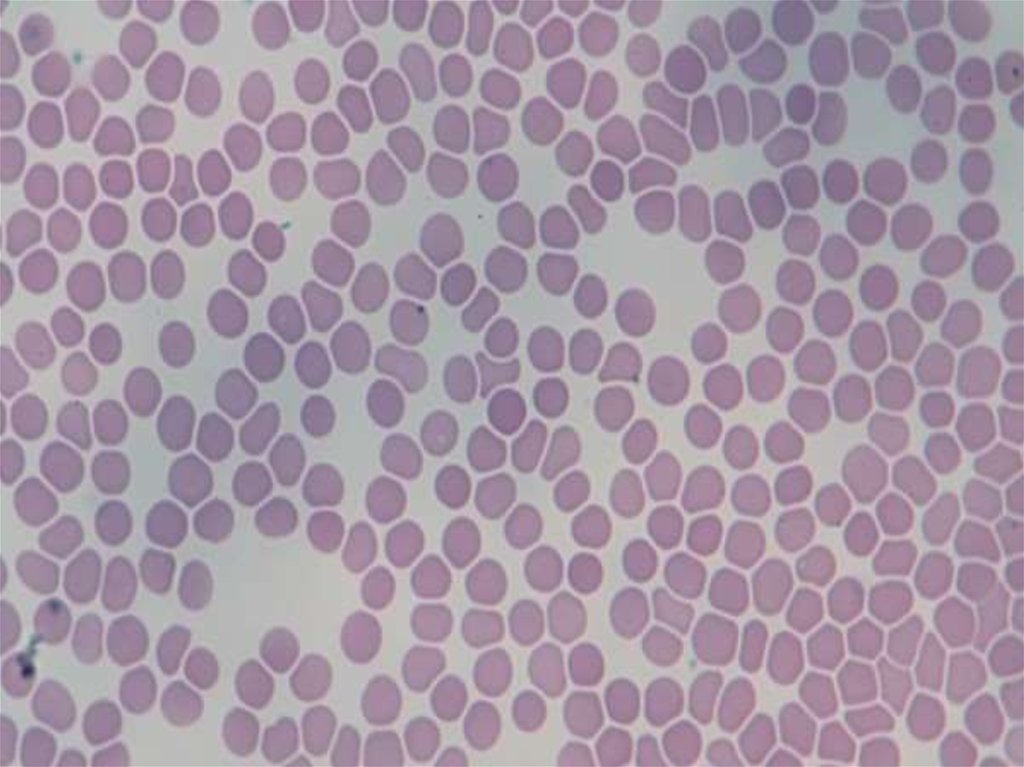

Похожие презентации:
Технологии в медицине
1. технологии в медицине
Кушнир Н.С.Аспирант центра теоретических проблем физико-химической фармакологии Российской
академии наук.
Младший научный сотрудник НМИЦ ДГОИ им. Дмитрия Рогачева.
Контакты: x-nekit@yandex.ru, 8-996-974-70-04.
1
2. Микроскопия
23.
34. Конфокальная микроскопия
45. Схема конфокального микроскопа
56. Принцип работы флуоресцентного и конфокального микроскопа
67.
78.
89.
910.
A Feature-Based Deep Learning Approach for Classification of Protein Networks Using 3DLive Microscopic Data
10
11. Распознавание образов, обработка изображений
1112. Реинфузия крови, излившейся в операционные полости
Реинфузия крови, излившейсяв операционные полости
12
13. Разделение крови на компоненты
1314.
1415. C.A.T.S. Plus
1516. Кровотечения и тромбозы
1617.
1718. Гемостаз
1819. Карта реакций механизма свертывания крови
Ansar S. Zhalyalov Mikhail A. Panteleev. Alexey M. Shibeko19
20. Тест тромбодинамики
2021. Схематическое изображение кюветы и типичные фотографии роста сгустка
2122. Образцы снимков, получаемых при исследовании плазм пациентов с различными патологиям
ИЗУЧЕНИЕ ВЛИЯНИЯ ТЕМПЕРАТУРЫ НА СОСТОЯНИЕ ПЛАЗМЕННОГО ГЕМОСТАЗА IN VITRO С ПОМОЩЬЮ МЕТОДАТРОМБОДИНАМИКИ И.А. Щербина1,3 , Е.Н. Липец1 , А.А. Абаева4 , А.Н. Баландина1,4 , Ф.И. Атауллаханов1,2,3,4,5 *
22
23. Включение лекарственных веществ в эритроциты человека
2324. Лейкозы
2425.
2526. Взаимодействие эритроцитов с растворами в зависимости от их осмотического давления.
Взаимодействие эритроцитов с растворами взависимости от их осмотического давления.
26
27. Принцип включения лекарственных веществ в эритроциты
28. Принцип действия устройства
Раствор кровис аспарагиназой
Насос
внутреннего
контура
Гипотонический раствор
Насос
внешнего
контура
Запечатанные
эритроциты
Слив
Датчик давления
Патрон
28

Медицина
Медицина








